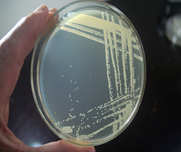
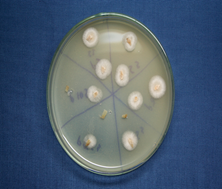
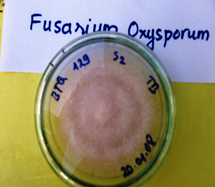

Chúng tôi đã xác định được 3 tác nhân gây ra hiện tượng vàng lá chết cây trên cây gừng, bao gồm:
1. Vàng lá chết nhanh do vi khuẩn:
Biểu hiện của triệu chứng này rất rõ, toàn bụi chuyển sang màu xanh vàng, cây héo và chết nhanh, giống như bị luộc, sau đó các thân gãy gục, củ bị thối nhũn và có mùi khó chịu, tốc độ lây lan trên ruộng rất nhanh theo dòng nước chảy. Nếu vụ sau cũng tiếp tục trồng trên đất đã bị bệnh thì gừng vẫn có triệu chứng tương tự. Bệnh thường xuất hiện gây hại mạnh trong mùa mưa, từ tháng 11 đến tháng 1 năm sau. Bệnh do một loại Vi khuẩn có tên là Ralstonia solanacearum gây ra.
|

Triệu chứng do Vi khuẩn(nhẹ)
|

Triệu chứng do Vi khuẩn(nặng)
|
|

Kiểm tra Vi khuẩn bằng
Pocket Diagnosis
|
Khuẩn lạc trên môi trường
King’B
|
2. Vàng lá chết chậm do nấm:
Triệu chứng đặc trưng của hiện tượng này là cây chết từ từ, ban đầu chỉ có 1 hoặc vài thân bị vàng, sau đó lan dần vào các thân bên trong và gây hại thân chính(thân mọc từ củ cái). Khi bị nặng, toàn bộ lá chuyển sang màu vàng đỏ, thân không gãy gục và củ thối như hiện tượng trên. Thường bị theo từng vạt, cây chết chậm và mức độ lây lan không lớn. Bệnh do nấm Fusarium oxysporum gây ra.
|

Triệu chứng do nấm Fusarium oxysporum trên gừng(nhẹ)
|

Triệu chứng do nấm Fusarium oxysporum trên gừng(nặng)
|
|
Phân lập nấm F.oxysporum trên môi trường PPA từ gừng
|
Làm thuần nấm F.oxysporum trên môi trường PDA
|
3. Vàng lá do tuyến trùng:
Thường biểu hiện trên toàn ruộng, lá chuyển sang màu vàng nhạt, cây còi cọc, sinh trưởng và phát triển kém, lá và thân nhỏ, ít ra thân mới. Đặc điểm rõ nhất là khi quan sát kỹ phần rễ, chúng ta có thể thấy những u sưng trên đó, nếu bị nặng thì rễ chuyển sang màu nâu đen và thối. Khi ruộng bị Tuyến trùng gây hại, nếu kết hợp với các tác nhân trên thì ruộng gừng sẽ chết nhanh hơn, do Tuyến trùng gây hại thường tạo ra những vết thương giúp cho nấm và vi khuẩn xâm nhiễm vào cây.
|

Triệu chứng do Tuyến trùng
|

Tuyến trùng ký sinh ở rễ
|
|
|

Tuyến trùng dưới kính hiển vi
|

Tuyến trùng dưới kính hiển vi(Phóng to)
|
(Còn nữa)